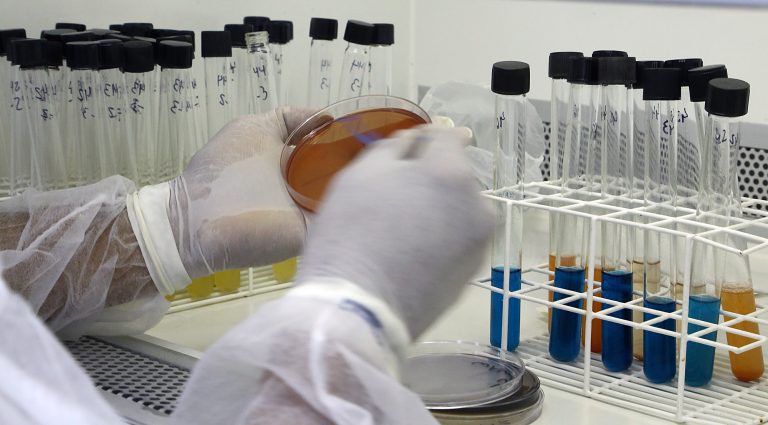
HoraMS Logo

Apesar do aumento do número de casos confirmados, as internações [...]
A 6ª edição da campanha Junho Lilás, iniciada no último [...]
Termina sexta-feira (3) a segunda etapa da Campanha Nacional de Vacinação [...]
A variação de preços cobrados por exames laboratoriais em Campo [...]
Últimas Notícias
Assine nossa newsletter
Fique por dentro das últimas notícias, só preencher abaixo.